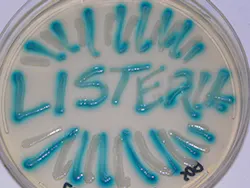
Beta Newequipment Com Sites Newequipment com Files Listeria Written On Petri Dish Beta Newequipment Com Sites Newequipment com Files Listeria Written On Petri Dish

In your facility, you have fire extinguishers, emergency escape signage, and maybe even a few automated external defibrillators hanging on the wall. The likelihood of someone suffering cardiac arrest in your building is slim, and the chance that someone nearby will have the wherewithal to provide the correct treatment in time is even slimmer. Still, would you feel better or worse if someone decided to remove the life-saving device?
Preparing for a product recall is sort of the same. It probably won’t happen to you, but having it could be the difference in saving your company’s life, or at least its reputation.
“It’s really important for manufacturers to have a plan to move forward quickly and get that product out of the consumers’ hands,” says Kevin Pollack Ready, vice president of Stericycle ExpertSOLUTIONS, a company that specializes in recall management.
photo credit: CDC.gov
As with any emergency response situation, it’s no surprise that speed is vital. The issue here is that you a company must quickly admit there is a flaw with its product, potentially life-threatening to the consumer and possibly due to negligence or error on the part of the manufacturer.
Nevertheless, Pollack strongly advises to get ahead of problem.
“The whole goal is to be as proactive as possible through the communication and to reach all the affected parties as quickly as possible,” he says.
These include issuing a press release, notifying all known customers from the warranty base, and informing distribution partners, and then contacting the people on their customer list. Because there are several nuances how this goes about, consulting professionals about a plan-of-action, whether it is Stericycle or another recall specialist, is the most sensible way to go.
“Ultimately that will make the recall happen more quickly, the company will be able to close it out more expediently and reach more consumers,” Pollack says.
Some of those nuances would appear in international recalls. According to Stericycle’s quarterly “Recall Index,” about one-third of FDA recalls involve multiple countries. Pollack says some recalls can involve more than 30 countries, each with its own regulatory agencies and languages. Trying to recall a Lithium-Ion battery, for example, could a be a logistical nightmare if handled alone. That’s because depending on the recall reason, the battery could now be deemed hazardous waste
“Most manufacturers never think about that because when it’s working fine you can transport however you want,” Pollack says. “The minute it becomes potential recall product whole set of regulations that have to be dealt with.”
Nearly half of all recalls, which is more than 130 million units, involve furnishings, housewares and appliances from 2010 to 2015, with eight deaths and 1,000 injuries related to the recalled products, according to Stericycle’s Q3 Recall Index.
As someone who worked in social media for cleaning manufacturer, I can attest to how you want to be the one to inform customers of a faulty or dangerous product. If it first appears in an Instagram or Twitter feed, the information will get disseminated quickly, but often with more “colorful” language and commentary than your company would prefer.
The easiest, most visible way to do this is through your company website.
“When a recall is actually launching, we recommend that it’s prominently featured on the company website and easy for consumers to find,” Pollack says. “That will help their management and reputation.”
And reputation is everything. Last spring, two separate ice cream producers -- Jenni’s Splendid Ice Cream, out of Columbus, Ohio, and Blue Bell Creameries based in Brenham, Tex., were forced to recall all their products in April due to unrelated listeria outbreaks.
WHITBY, ENGLAND - APRIL 27: Cyber Goth James Kirby stands outside an ice cream parlour at the start of Whitby Goth Weekend on April 27, 2012 in Whitby, England. Whitby Gothic Weekend which started in 1994 to celebrate all things dark and mysterious has now grown to a twice yearly event for Goths. Whitby was partly chosen because Bram Stoker wrote his famous Dracula story in the fishing town with the Gothic Whitby Abbey as his inspiration. The weekend has now grown from providing a few bands to include followers of Romanticism, Victoriana, Cybergoth and Steampunk. (Photo by Christopher Furlong/Getty Images)
The bacterium withstands cold temperatures and is found in raw meat and dairy products. Listeriosis includes symptoms such fever and headaches, and can be fatal to newborns, pregnant women, older adults, and those with weakened immune systems.
The Blue Bell recall in March 2015 was attached to three deaths in a Kansas hospital. It wasn’t the primary cause, though, according to the Kansas Department of Health and Environment.
Still, the U.S. Department of Justice is investigating the company and its recall, which was the first for the 108-year-old company. The Center for Disease Control says the same strain of listeria was discovered in 2010, though a recall didn’t transpire until after three people had died. A complete recall and shutdown wasn’t initiated until more than a month later. Because of the shutdown, the fourth-largest ice cream maker had another first: layoffs. In May, 1,450 employees were laid off.
In contrast, Jeni’s listeria problem was discovered by a routine Nebraska Department of Agriculture at a Whole Foods in Lincoln. The company swabbed its entire production facility and found more listeria, immediately announcing a total recall. The company reported this meant destroying 265 tons of ice cream, worth $2.5 million. Making the best of a bad situation, the waste was taken to an anaerobic digester and created 90,430 kw/hr.
On the company blog, founder and namesake Jeni Britton Bauer wrote: We had in-house testing and a regulatory manager to make sure we followed all standards. We had no reason to think we weren’t absolutely solid in the safety department. Still, we had a blind spot: we had an insufficient Listeria control program. For that, we take full responsibility and make no excuses.
Being mentally prepared to accept responsibility and take accountability can actually create more public goodwill and brand awareness than prior to the recall.
“If handled well, it can be a benefit to the brand because they see the company cares about the customer and did everything right,” Pollack says. “They come out relatively unscathed or in a better position. Others who have been perceived to not have done the right thing, or react too slowly or haphazardly can see negative effects, and that lingers on and bad press potentially for years.”
For more information on Stericycle, visit the company website or email: [email protected]
About the Author
John Hitch
Editor, Fleet Maintenance
John Hitch, based out of Cleveland, Ohio, is the editor of Fleet Maintenance, a B2B magazine that addresses the service needs for all commercial vehicle makes and models (Classes 1-8), ranging from shop management strategies to the latest tools to enhance uptime.
He previously wrote about equipment and fleet operations and management for FleetOwner, and prior to that, manufacturing and advanced technology for IndustryWeek and New Equipment Digest. He is an award-winning journalist and former sonar technician aboard a nuclear-powered submarine where he served honorably aboard the fast-attack submarine USS Oklahoma City (SSN-723).